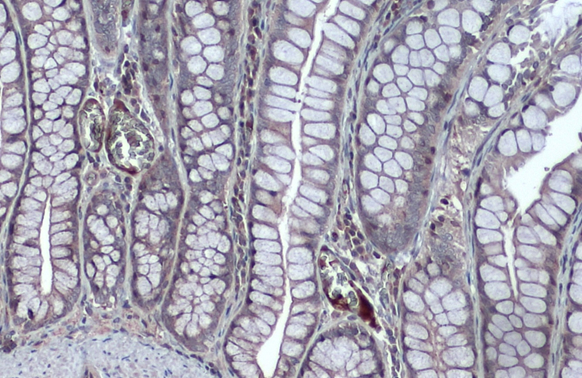
NFkB p105 antibody detects secreted NFkB p105 protein by immunohistochemical analysis. Sample: Paraffin-embedded dog colon. NFkB p105 stained by NFkB p105 antibody (GTX110585) diluted at 1:500. Antigen Retrieval: Citrate buffer, pH 6.0, 15 min

anti-NFkB p105 phospho (Ser927) antibody
ARG51786
ApplicationsImmunoFluorescence, Western Blot, ImmunoCytoChemistry, ImmunoHistoChemistry, ImmunoHistoChemistry Paraffin
Product group Antibodies
ReactivityHuman
TargetNFKB1
Overview
- SupplierArigo Biolaboratories
- Product Nameanti-NFkB p105 phospho (Ser927) antibody
- Delivery Days Customer23
- Application Supplier Note* The dilutions indicate recommended starting dilutions and the optimal dilutions or concentrations should be determined by the scientist.
- ApplicationsImmunoFluorescence, Western Blot, ImmunoCytoChemistry, ImmunoHistoChemistry, ImmunoHistoChemistry Paraffin
- CertificationResearch Use Only
- ClonalityPolyclonal
- Concentration1 mg/ml
- ConjugateUnconjugated
- Gene ID4790
- Target nameNFKB1
- Target descriptionnuclear factor kappa B subunit 1
- Target synonymsCVID12, EBP-1, KBF1, NF-kB, NF-kB1, NF-kappa-B1, NF-kappaB, NF-kappabeta, NFKB-p105, NFKB-p50, NFkappaB, nuclear factor NF-kappa-B p105 subunit, DNA-binding factor KBF1, nuclear factor NF-kappa-B p50 subunit, nuclear factor kappa-B DNA binding subunit, nuclear factor of kappa light polypeptide gene enhancer in B-cells 1
- HostRabbit
- IsotypeIgG
- Protein IDP19838
- Protein NameNuclear factor NF-kappa-B p105 subunit
- Scientific DescriptionNF-kappa-B is a pleiotropic transcription factor which is present in almost all cell types and is involved in many biological processed such as inflammation, immunity, differentiation, cell growth, tumorigenesis and apoptosis. NF-kappa-B is a homo- or heterodimeric complex formed by the Rel-like domain-containing proteins RELA/p65, RELB, NFKB1/p105, NFKB1/p50, REL and NFKB2/p52 and the heterodimeric p65-p50 complex appears to be most abundant one. The dimers bind at kappa-B sites in the DNA of their target genes and the individual dimers have distinct preferences for different kappa-B sites that they can bind with distinguishable affinity and specificity. Different dimer combinations act as transcriptional activators or repressors, respectively.
- ReactivityHuman
- Storage Instruction-20°C
- UNSPSC41116161